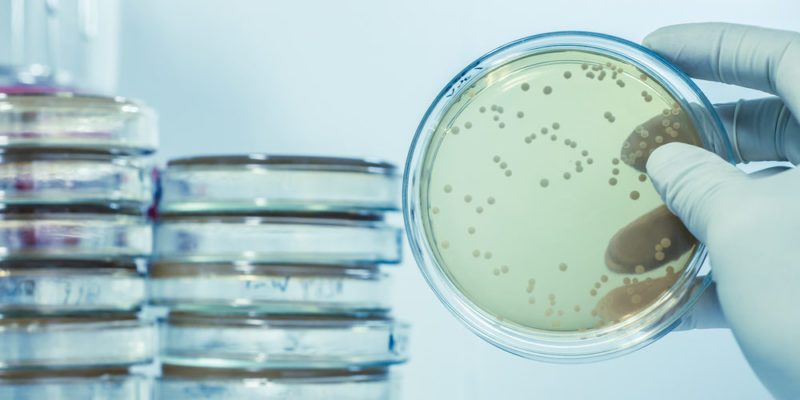
Microbiología y Parasitología Microbiología y Parasitología

Microbiología y Parasitología
Bienvenido al curso de Microbiología y Parasitología. A lo largo de las próximas semanas, exploraremos temas fascinantes que te ayudarán a desarrollar nuevas habilidades y conocimientos. Nuestro objetivo es crear un ambiente amigable y colaborativo donde todos puedan disfrutar del proceso de aprendizaje!
Bienvenido
Microbiología y Parasitología
Precio:
$26